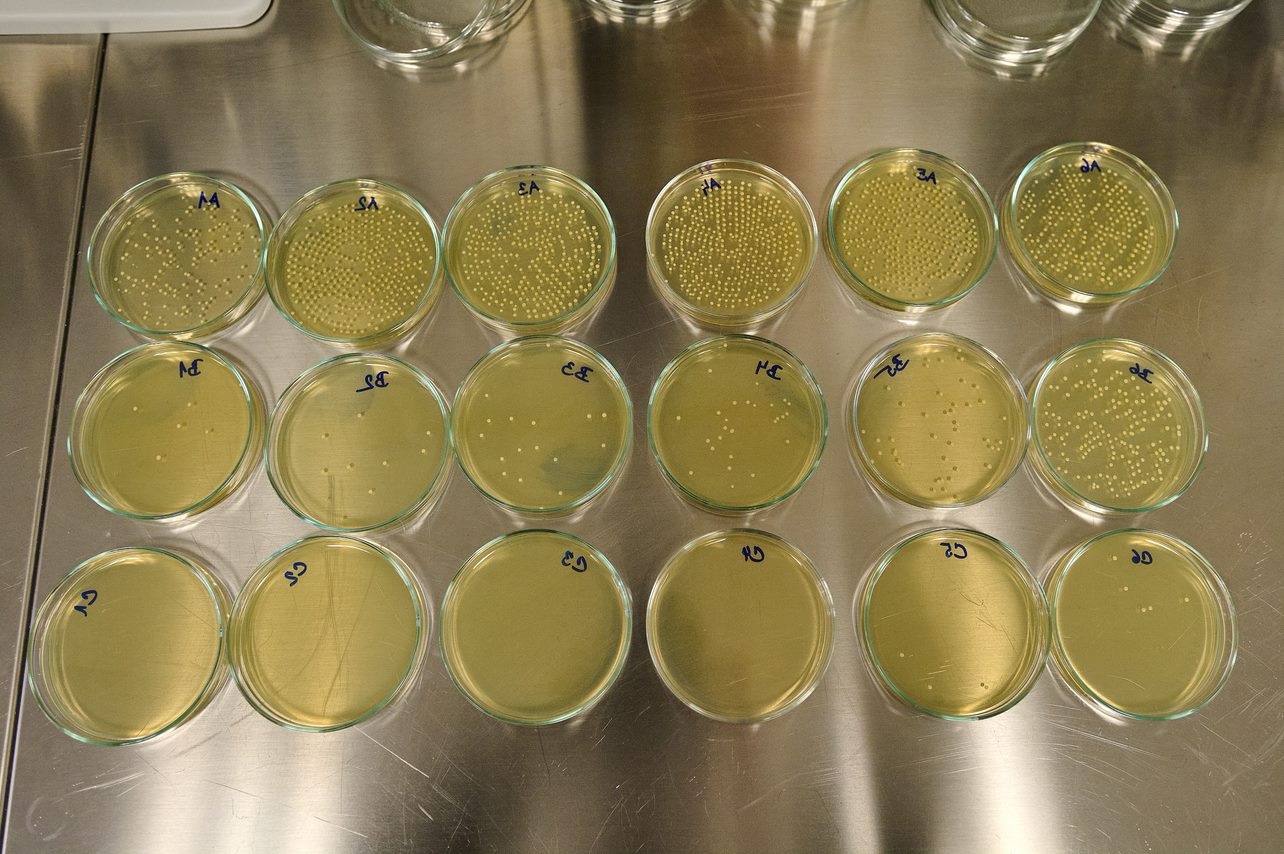

Ve Zlíně spustili testování zdravotnických roušek. U nás jako jediní.
Zlín 20.4.2021 - Univerzita Tomáše Bati (UTB) ve Zlíně začala testovat bakteriální filtrační účinnost jednorázových chirurgických roušek. Testování se realizuje v Centru polymerních systémů (CPS) ve spolupráci se zlínským Institutem pro testování a certifikaci (ITC). Testy chirurgických roušek provádí podle požadované závazné normy pro zdravotnické prostředky (ČSN EN 14683+AC:2020).
Během testu dochází k simulaci potencionálního nakaženého uživatele, který vydechuje infekční kapénky. Během tohoto testu lze tedy bezpečně zjistit, jak moc daná rouška tento nebezpečný aerosol zachytí. „Máme tady speciální přístroj - nebulizér, který vytváří aerosol obsahující bakterie Staphylococcus aureus neboli zlatého stafylokoka. Pokud rouška funguje správně, musí odfiltrovat minimálně 95 % aerosolu s tímto stafylokokem,“ popisuje samotný průběh testu prof. Vladimír Sedlařík, ředitel CPS a rektor zlínské univerzity. „Zjednodušeně si lze představit, že začátek aparatury simuluje nemocného člověka, který vydechuje aerosol s bakteriemi do prostředí, a my pak stanovujeme procentuální průnik bakterií skrz roušku,“ doplňuje Hana Pištěková, vědecká pracovnice z Centra polymerních systémů, která roušky testuje.
 K otestování jedné roušky daného výrobce dle všech požadavků normy je potřeba pětasedmdesát kusů. Doba trvání všech potřebných testů je přibližně čtyři až osm týdnů, dle vytíženosti laboratoře. Testování chirurgických roušek je určeno pro všechny subjekty, které vyrábí nebo dováží tyto výrobky, tj. klasické, jednorázové zdravotní roušky. Zjistit, zda rouška prošla testem, či ne, trvá několik týdnů. „Vzájemná spolupráce mezi zlínskou univerzitou a institutem poskytuje výrobcům těchto zdravotnických prostředků unikátní možnost zkoušek dle ČSN EN 14683 de facto na jednom místě.
K otestování jedné roušky daného výrobce dle všech požadavků normy je potřeba pětasedmdesát kusů. Doba trvání všech potřebných testů je přibližně čtyři až osm týdnů, dle vytíženosti laboratoře. Testování chirurgických roušek je určeno pro všechny subjekty, které vyrábí nebo dováží tyto výrobky, tj. klasické, jednorázové zdravotní roušky. Zjistit, zda rouška prošla testem, či ne, trvá několik týdnů. „Vzájemná spolupráce mezi zlínskou univerzitou a institutem poskytuje výrobcům těchto zdravotnických prostředků unikátní možnost zkoušek dle ČSN EN 14683 de facto na jednom místě.

Pozitivní výsledek těchto zkoušek je jednou, nikoliv však jedinou, nutnou náležitostí pro uvádění těchto výrobků na jednotný trh Evropské unie,“ říká Ing. Jiří Samsonek, ředitel divize zkušebnictví ITC, který testování roušek komplexně zastřešuje. „Dosud si firmy musely nechat testovat tyto výrobky v zahraničí. Nyní jsme konečně schopni provádět požadované testy také v České republice, včetně tohoto klíčového,“ dodává Jiří Samsonek. Jednou ze společností, která své výrobky v Centru polymerních systémů testuje, je zlínská firma SPUR.

Ta společně s univerzitou vyvíjí nanomateriál, který je schopen zachytit koronavir. "Jsme rádi, že laboratoře zlínské univerzity jako jediné v České republice toto povinné testování filtrace bakteriální infekce u roušek zajišťují. Těší nás to o to víc, že jde o univerzitu, s níž dlouhodobě úspěšně spolupracujeme," uvedl Tomáš Dudák, generální ředitel společnosti SPUR, a dodal: "Testování roušek přispívá k dosažení naší společné snahy poukázat na nepoctivé prodejce, kteří v podstatě bez jakéhokoli postihu ohrožují zdraví lidí nekvalitními výrobky."

 K otestování jedné roušky daného výrobce dle všech požadavků normy je potřeba pětasedmdesát kusů. Doba trvání všech potřebných testů je přibližně čtyři až osm týdnů, dle vytíženosti laboratoře. Testování chirurgických roušek je určeno pro všechny subjekty, které vyrábí nebo dováží tyto výrobky, tj. klasické, jednorázové zdravotní roušky. Zjistit, zda rouška prošla testem, či ne, trvá několik týdnů. „Vzájemná spolupráce mezi zlínskou univerzitou a institutem poskytuje výrobcům těchto zdravotnických prostředků unikátní možnost zkoušek dle ČSN EN 14683 de facto na jednom místě.
K otestování jedné roušky daného výrobce dle všech požadavků normy je potřeba pětasedmdesát kusů. Doba trvání všech potřebných testů je přibližně čtyři až osm týdnů, dle vytíženosti laboratoře. Testování chirurgických roušek je určeno pro všechny subjekty, které vyrábí nebo dováží tyto výrobky, tj. klasické, jednorázové zdravotní roušky. Zjistit, zda rouška prošla testem, či ne, trvá několik týdnů. „Vzájemná spolupráce mezi zlínskou univerzitou a institutem poskytuje výrobcům těchto zdravotnických prostředků unikátní možnost zkoušek dle ČSN EN 14683 de facto na jednom místě.
Pozitivní výsledek těchto zkoušek je jednou, nikoliv však jedinou, nutnou náležitostí pro uvádění těchto výrobků na jednotný trh Evropské unie,“ říká Ing. Jiří Samsonek, ředitel divize zkušebnictví ITC, který testování roušek komplexně zastřešuje. „Dosud si firmy musely nechat testovat tyto výrobky v zahraničí. Nyní jsme konečně schopni provádět požadované testy také v České republice, včetně tohoto klíčového,“ dodává Jiří Samsonek. Jednou ze společností, která své výrobky v Centru polymerních systémů testuje, je zlínská firma SPUR.

Ta společně s univerzitou vyvíjí nanomateriál, který je schopen zachytit koronavir. "Jsme rádi, že laboratoře zlínské univerzity jako jediné v České republice toto povinné testování filtrace bakteriální infekce u roušek zajišťují. Těší nás to o to víc, že jde o univerzitu, s níž dlouhodobě úspěšně spolupracujeme," uvedl Tomáš Dudák, generální ředitel společnosti SPUR, a dodal: "Testování roušek přispívá k dosažení naší společné snahy poukázat na nepoctivé prodejce, kteří v podstatě bez jakéhokoli postihu ohrožují zdraví lidí nekvalitními výrobky."


